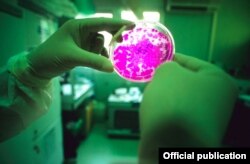
Жапон окумуштуулары жасаган "мини боор".

Кара материалдын касиети
Жаңы материал VantablackS-VIS деп аталып, бетине түшкөн жарыктын 99, 965% өзүнө сиңирип аларын Британиянын Surrey NanoSystems компаниясы маалымдады.
Ал алюминий негизге кычкылтек нанотүтүкчөлөрдү өстүрүү жолу менен алынган. Жаңы материал оптикалык электроникалык приборлордо же телескоптордо алыскы жылдыздарды көрүү, Күн нурунун кубатын жыйноо, проекциялык лазердик системалардын ишин жакшыртуу жана аскерий маскировка үчүн пайдаланылышы мүмкүн.
VantablackS-VIS материалы Hubble космостук телескобунда колдонулган кара материалга караганда жарыкты 17 эсе аз чагылдырат.
Ошондуктан жарыктын нурун минималдаштырып, жылдыздардын абдан сапаттуу сүрөтүн алганга мүмкүндүк берет.
Тарыхтагы эң кара материал 2014-жылы жасалган. Syrrey NanoSystems компаниясынын өкүлү Бен Женсен (Ben Jensen): “Азыркы колдо бар коммерциялык абсорберлерге салыштырганда чоң кадам алга ташталды”, - дейт. (Булагы: www.surreynanosystems.com)
Жапонияда “мини боор” жасалды
Йокагама университетинин профессору Хидэки Танигути (Hideki Taniguchi) башындагы адистер тобу адамдын организминен кем эмес иштеген “мини боорду” жасашты. Ал үчүн түрдүү органдардын клеткаларын жарата алчу плюрипотенттик сөңгөк клеткалары (IPS) пайдаланылган. Кичинекей жасалма боор адамдын боору сыңары эле альбумин белокторун жана аммиакты иштеп чыгат.
Жапониянын NHK телеканалынын кабарлашынча, жасалма боорду имплантациялоо иши 2019-жылы башталат деп мерчемделүүдө.
2006-жылы Киото университетинин профессору Синья Яманка сөңгөк клеткасын адамдын тери клеткасынан алган. Ал клеткалар индуцирленген көп функционалдуу (плюрипотенттик) сөңгөк клеткалары (IPS) деп аталган. Натыйжада оорудан жана башка себептерден улам иштен чыккан клеткаларды алмаштырчу ткандар менен органдарды жасоого жол ачылган. Ал эмгеги үчүн Синья Яманкага 2012-жылы Нобель сыйлыгы ыйгарылган.
Абасы кир жерди көгүчкөндөр аныктайт
Ал үчүн 10 көгүчкөндүн желкесине тырнактай сенсор байланып, учурулат. 25 граммдык сенсор озондун деңгээлин, азот диоксини жана башка зыяндуу заттарды аныктайт. Көгүчкөндөр кайда жүргөнү GPS аркылуу көзөмөлдөнүп турат. Бул канаттуулар 30-45 метр бийикте жана 128, 75 км/саат ылдамдыкта уча алат.
“Булганч аба жөнүндө сөз болгондо адамдар Бээжинди ойлошот. Бирок Лондондо аба жылына бир нече жолу Бээжинге караганда көп жана коркунучтуу булганат”, - дейт баш кеңсеси Лондондо жайгашкан DigitasLBi компаниясынын жетекчилеринин бири Пьер Дюкенуа (Pierre Duquesnoy) The Gardian гезитине.
15 жыл мурда Мехикодо шаардын абасы булганган жерлерин тактоо үчүн денесине чип (сенсор) орнотулган 150 жолбун ит пайдаланылган.
Тамекини таштоо оңой эмес...
Чеккен тамекинин санын акырындап азайтам деген адамдын тамекини таштоосу көк түтүндү буркураткан адамга караганда бир кыйла аз. Британ илимпозу Никола Линдсон-Хоули (Nicola Lindson-Howley) айым жана анын кесиптештери тамеки чегүүнү таштагысы келген 700дөй адам менен өткөрүлгөн эксперименттен соң ушундай тыянак жасашты. Эксперимент үчүн күнүнө кеминде 15 чылым тарткан адамдар тандалып алынган.
Алардын бир тобу чылым чеккенди алгачкы күнү токтотушса, экинчи топтогулар эки жумадан соң токтотобуз дешип, күн сайын тамекинин санын азайтышкан.
Эки аптадан соң 1-топтогулардын 49%, 2-топтогулардын 39% түтүн булатпай калган. Каалоочулар үчүн тамеки жыттуу сагыз, момпосуй же спрей эркин коюлган. Алты ай бою алар сурамжыланып жана дем алганда бөлгөн көмүртектин моноокисинин концентрациясы ченелип турган.
Жарым жылдан кийин 1-топтогулардын 22%, 2-топтун 15% чылым чекпей калган. Ушундан улам тамеки тартпайм деп чечкиндүү бел байлаган адамга зыяндуу адаттан арылуу жеңил болот, - дешет Оксфорд университетинин изилдөөчүлөрү. (Караңыз: Time.com)